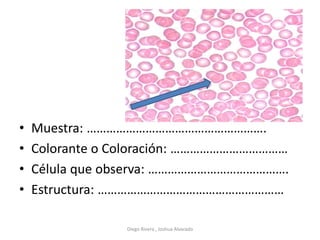
• Muestra: ……………………………………………….
• Colorante o Coloración: ………………………………
• Célula que observa: …………………………………….
• Estructura: …………………………………………………
Diego Rivera , Joshua Alvarado
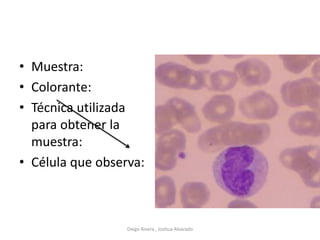
• Muestra:
• Colorante:
• Técnica utilizada
para obtener la
muestra:
• Célula que observa:
Diego Rivera , Joshua Alvarado
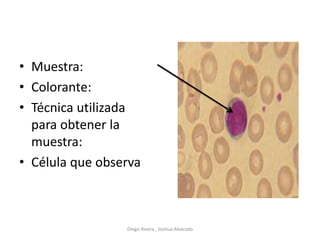
• Muestra:
• Colorante:
• Técnica utilizada
para obtener la
muestra:
• Célula que observa
Diego Rivera , Joshua Alvarado
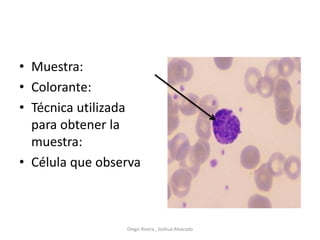
• Muestra:
• Colorante:
• Técnica utilizada
para obtener la
muestra:
• Célula que observa
Diego Rivera , Joshua Alvarado
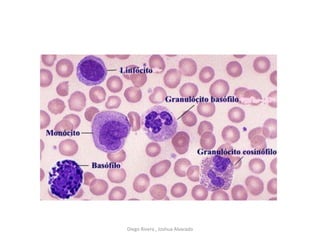
Diego Rivera , Joshua Alvarado

Este documento contiene preguntas y respuestas sobre diversos temas de biología. Incluye preguntas sobre los componentes y funciones del microscopio, tipos de microscopios, niveles de organización biológica, células procariotas y eucariotas, ciclo celular, gametogénesis y ovogénesis. El documento proporciona información sobre conceptos fundamentales de biología celular y microbiología a través de preguntas y respuestas breves.